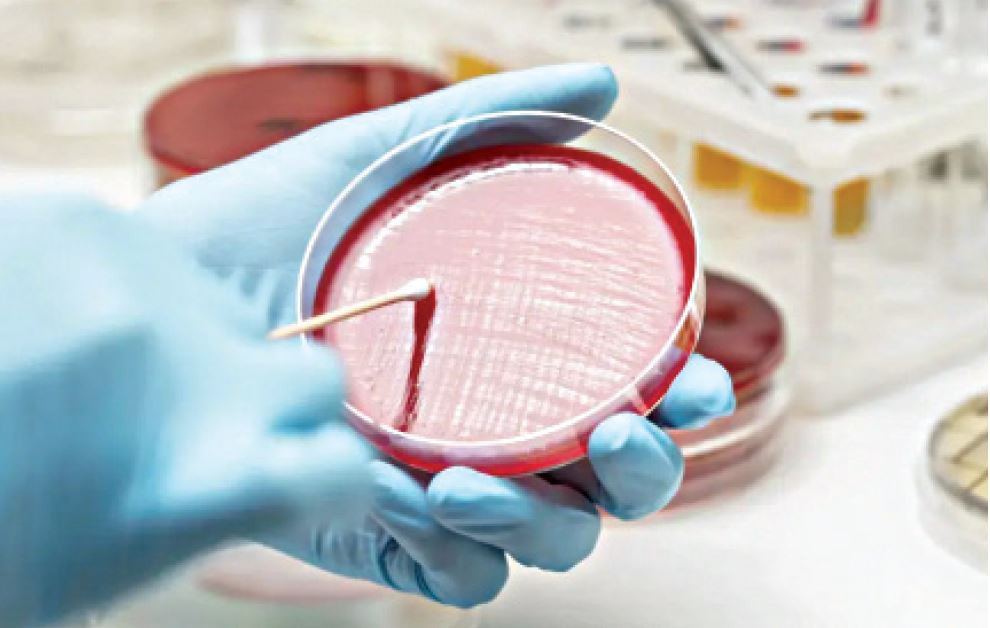

2021 жылы – 6, 2022 жылы – 4, 2023 – 8. Ал 2024 жылы 19 дерегі анықталды! Яғни, 1 ғана жылдың көрсеткіші үш жылды қоса алғандағыдан асып түсті. Бұған не себеп? Отандық ғалымдар індет ошағы болған қорымдарды зарарсыздандырып, түпкілікті арылуды ұсынып еді, бұл идея неге ілгері баспады?
Атырауда ахуал алаңдатады
Бұған дейін Денсаулық сақтау министрлігі биылғы он айдың қорытындысында Қазақстанда күйдіргіге душар болудың 17 дерегі әшкереленгенін жариялаған болатын. Содан бері елде кем дегенде тағы 2 дерегі анықталды. Екеуі де Атырау облысында.
Адамдар бұл індетті үй жануарларынан, ауру малдың шикі етінен және топырақтан жұқтырады. Ведомство мамандарының түсіндіруінше, күйдіргі немесе сібір жарасы – адамның, ауыл шаруашылығы және жабайы жануарлардың ағзасына еркін кіріп алатын аса қауіпті инфекциялық ауру. Уақытылы емдемесе, дерті тез меңдеп, өлімге соқтыруы мүмкін. Оның қоздырғышы – «Сібір жарасы микробы» топырақта ұзақ жылдар бойы сақталады.
Оның теріні, өкпені және ішек-қарын жүйесін зақымдайтын түрлері болатындықтан, симптомдары да әртүрлі, оларды шағын мақалада үзіп-жұлып келтіре салу адамдарға теріс түсінік берумен тең болар еді. Денсауминінің Ұлттық қоғамдық денсаулық сақтау орталығының мамандары індеттен сақтану үшін азаматтарға ет пен ет өнімдерін санитарлық-ветеринарлық бақылауы жоқ, белгіленбеген жерде сауда жасайтын адамдардан сатып алмауға кеңес береді.
Мамандардың айтуынша, қорасында мал ұстайтын ауылдықтар жеке гигиена шараларын сақтауы, төрт түлігін вакцинациялауы, ауру немесе өліп қалған жануарды ветеринардың куәландыруынсыз, өз бетінше соймауы қажет. Етті кем дегенде 70°C температурада ұзағырақ пісіру, жартылай шикі күйінде жемеу керектігі айтылды. Шикі етті кесіп, тураған соң қолды, пышақты, өзгесін мұқият жуған маңызды.
Дәрігерлер сібір жарасының адамнан адамға берілмейтінін, тек малдан не оның өнімдерінен жұғатынын ескертті. Базардан ет алғанда өнімнің қауіпсіздігін растайтын ветеринарлық қорытындыны талап еткен жөн. Денсаумині мал шаруашылығы шикізатын сатумен, өңдеумен, тасумен айналысатын жұмысшыларды жеке гигиенаны, профилактика шараларын сақтауға шақырды. Себебі күйдіргі базарлардан табылды.
Өткен апта соңында сібір жарасының таралу қатеріне бола, Атырауда базар жабылды. Өңірлік Санитарлық-эпидемиологиялық бақылау департаментінің хабарлауынша, мамандар сауда орындарын қайталама тексеру кезінде індет нышандарын тапты. Экспресс-тест эпидемиологтардың қаупін растады.
– Дезинфекциялық іс-шаралар жүргізу үшін базар жабылды. Осының алдында департамент мамандары қалада ет сатумен айналысатын 65-тен астам сауда орнын тексеріп, 700-ден астам сынама алған еді. Оның бәрі теріс нәтиже көрсеткен. Бірақ қайталама тексеру кезінде қосымша үлгілер алынды, олар Ұлттық санитарлық-эпидемиологиялық сараптама орталығында тексеруден өтіп жатыр, – деді департамент мамандары.
Ақпарат құралдары сібір жарасының микробтары Атыраудағы «Дина» орталық базарынан табылғанын жазды. Департамент өкілдері ауру қоздырғыштары пышақтан алынған сынамадан анықталғанын нақтылады. Ет павильоны жабылып, дезинфекциялау шаралары жүргізілген. Онда жұмыс істеген дара кәсіпкерлердің, саудагерлердің тізімі түзілді. Олар 14 күн бойы медициналық бақылауда болады.
Еске сала кетсек, Аikyn газеті қараша айының басында Атыраудағы «Асыл Агро» базарының мал сою цехының жұмысшысынан күйдіргінің тері формасы табылғанын бұған дейін жазды («Күйдіргі күйдіріп барады»). Ай соңында оның тағы бір әріптесі дәрігерге жүгінген.
Алматы жақта арнайы топ құрылды
Індеттің аққұла биыл қанат жаюы Үкіметті де алаңдатып отыр. Ахуалды талқылауға арналған алғашқы жабық отырыс 2024 жылғы 13 қыркүйекте өткен болатын. Хаттамадан белгілі болғандай, онда жауапты органдарға және әкімдерге «сібір жарасының туындауы мен таралуына жол бермеу үшін жүйелі шаралар қабылдау, уәкілетті мемлекеттік органдарға сібір жарасы көмілген жерлер мен мал қорымдарының тізімдерін жаңартып, оларға ревизия жүргізу жөніндегі өңірлік комиссиялар құру» туралы тапсырмалар берілді. Қазір құрамына мүдделі ведомстволардың мамандары кірген тиісті комиссия осы жүктелген жұмыстарды жүргізіп жатыр.
Жергілікті тұрғындардың шағымдарынан белгілі болғандай, Алматы облысының Іле ауданында орналасқан Қараой және Н.Тілендиев ауылдарында жұртшылыққа үй салуға, егін салып, жер пайдалануға рұқсат етілген аумақтардан сібір жарасына шалдыққан жануарларды көму орындары табылған. Тұрғындар ол жерлерге үй салып үлгеріпті, енді құжаттарын рәсімдеу ғана қалғанда, жер учаскелерінің пайдалануға беруге жатпайтыны әшкереленіп, халық ұлардай шулап қалды.
Депутаттар Қазақстан бойынша мұндай жағдайдың көп кездесетінін айтады. Неге әкімқаралар жер учаскелерін таратқанда алдын ала зерттеулер жүргізбеген деген сауал туындайды. Денсаулық сақтау министрінің 2021 жылғы 12 қарашадағы №ҚР ДСМ-114 бұйрығына сәйкес, күйдіргі ошақтарының санитариялық-қорғаныш аймағындағы жер учаскелерін агромелиоративтiк, барлау, гидромелиоративтік, құрылыс жұмыстарын жүргізуге бөлуге, сондай-ақ жалға беруге, жекеменшікке сатуға тыйым салынған.
Ресми дерек бойынша, Қазақстан территориясында халықтың денсаулығы мен ұлттық қауіпсіздікке үлкен қауіп-қатер төндіретін сібір жарасы көмілген ошақ-орындарының саны – 2 162. Оның басым бөлігі елді мекендерде орналасқан екен. Осындай қауіпті қорымдардың бірі Алматының Медеу ауданында тұр. Түркістан қаласында, сондай-ақ Ақтөбедегі «Нұр Ақтөбе» шағынауданында жаңа мектепке жақын орналасқан қорымдар жергілікті жұртшылықтың жүрегін суылдатады.
Мәжіліс депутаттары Қосшыдағы сондай қорым су қоймасына жақын орналасқандықтан, судың ластануы қаупін төндіріп тұр дейді. Зайсан әуежайы осылай ластанған аумақтарға жақын болғандықтан, онда заманауи ұшақтар қона алуы үшін ұшу-қону жолағын ұзарту мүмкін болмапты. Республика бойынша ауылдардың әрқайсысында дерлік осындай қорымдар, індет ошақтары бар.
Сарапшылар олардың бәрінің бірдей орналасқан жері, схемасы картаға түсірілмеген деген қорқынышты болжам айтады. Елімізде сібір жарасы бойынша кадастрдағы деректердің дәлдігі күмән тудыратын көрінеді. Қазір қолданылатын ғылыми кадастрларды тиісті министрлік бекітпегендіктен жергілікті әкімдіктер жер телімдерін беру кезінде бұл құжатқа ресми түрде сүйене алмайтын көрінеді.
Алматы өңіріндегі қос ауылдан шыққан дау-жанжалдың дүмпуі жоғарыға жетті. Содан Алматы облысының әкімі Марат Сұлтанғазиевтің 2024 жылғы 4 қазандағы №58-өн/қ өкімімен, жұмыс тобы құрылды. Оған кеңес заманынан бері сібір жарасына шалдыққан малдардың өлекселері көмілген жерлердің координаттарын нақтылау, оларды ветеринариялық-санитариялық қағидалардың талаптарына сәйкес келтіру және санитариялық-қорғау аймағына кіретін жер учаскелеріне қатысты тиісті жұмыстарды жүзеге асыру тапсырылды. Топ жыл соңына дейін осы бағыттағы жұмысын жалғастыратыны айтылды.
Кадастрға сәйкес, Алматы облысының Қараой ауылында сібір жарасы бойынша бір ғана стационарлық пункт тіркеліпті. Онда 1959 жылы өлген жалғыз ірі қара мал көмілген екен. Н.Тілендиев (Шелек кемер) ауылында індет ошақтарының саны 3-еу: оларда 1968, 1969, 1970-жылдары қырылған сиырлардың өлексе-сүйектері жатыр.
Үкімет өкілдері сарапшылардың «ғылыми кадастрларды тиісті министрлік бекітпеген» деген ақпаратты растамады. Сібір жарасы көмілген жерлердің координаттары, індеттің эпизоотиялық, эпидемиялық ошақтары туралы мәліметтер Денсаулық сақтау министрлігінің 2003 жылғы 5 қаңтардағы және Ауыл шаруашылығы министрлігінің сол жылғы 31 қаңтардағы бұйрықтарымен бекітілген «1948-2002-жылдары Қазақстан Республикасының сібір жарасы бойынша стационарлық қолайсыз елді мекендерінің кадастрында» ұсынылыпты. Бірақ ол бәрібір нақтылауды қажет етеді.
Толық құтылуға болмас па?
Қазақстан ғалымдары ресейлік әріптестерімен бірлесіп, сібір жарасын зарарсыздандыратын «ВА-12» атты жаңа дәрі ойлап тапқан-тын. Ол туралы біраз айтылды. Артынан тыншып қалды. Мәжіліс депутаты Ержан Бейсенбаев Ауыл шаруашылығы министрлігінің тапсырмасымен, «КазНИВИ» ЖШС базасында «Сібір жарасының топырақ ошақтарын дезинфекциялау және жою» жобасы жүзеге асырылғанын жеткізді.
– Жоба аясында «КазНИВИ» ЖШС қызметкерлері ресейлік «НИКА» ЖШС мамандарымен бірге, «ВА-12 дезинфекциялық ветеринариялық өнімін» әзірлеп шықты. Ол препарат комиссиялық тіркеу сынақтарынан өтіп, тіркеу куәлігін алды. Зерттеулер нәтижесінде анықталғандай, бұл дәрі жер бетінен жеткілікті тереңдікте орналасқан сібір жарасының ошақтарын жоюға қабілетті! Бұл жаңалық ел экономикасы мен халық денсаулығына үлкен пайда әкеле алады. Инфекцияның таралу қаупін едәуір төмендетеді. Алайда оның тиімділігін тәжірибеде көрсету үшін далалық сынақтар жүргізу қажет, – деді Ержан Алмабекұлы.
Оның айтуынша, күйдіргі ошақтарынан «арылуға» мүмкіндік болуы үшін мемлекет ғылыми-зерттеу жұмыстарына қолдау көрсетуге тиіс. Ғалымдар парламентшілерден сібір жарасы ошақтарының санитариялық-эпидемиялық жағдайын қалыптастыру үшін практикалық шараларды іске асыруға жәрдемдесуді сұрапты.
Сондықтан Мәжілістің бір топ депутаты сібір жарасының ошақтарын залалсыздандыруға арналған отандық «ВА-12» препаратына қатысты әзірлемелер мен зерттеулерді қолдауды және қаржыландыруды арттыруды сұрап, Үкіметке жүгінді. Олардың пікірінше, бұл препаратты тиімді пайдалану тәуекелдерді айтарлықтай азайтады және зардап шеккен аймақтарда қауіпсіздікті қамтамасыз етеді.
Алайда ғалымдар мен депутаттардың бастамасы Үкіметте қолдау таппағаны енді белгілі болып отыр. Министрлер кабинеті ол ұсынысты қарады. Неге құптамады? Оның мәнісін Мәжіліске Үкімет басшысы Олжас Бектеновтың өзі түсіндіріп берді.
Ауыл шаруашылығы министрлігінің дерегінше, «БА-12» дезинфекциялау құралы ветеринариялық-санитариялық қадағалау объектілері мен топырақты профилактикалық және мәжбүрлі дезинфекциялауға арналған. Ол шынында да АШМ-нің Ветеринариялық препараттар мен жемшөп қоспаларының мемлекеттік тізілімінде тіркелген.

Үкімет сарапшы деп тартқан зерттеушілерді шошынтқаны сол, «БА-12» дезинфекциялау құралының құрамына әмбебап антисептик және тиімді илік зат саналатын «глутар альдегиді» (кем дегенде 10%) кіреді. Балама атауы – пентадиаль. Ол медицина, ветеринария, мал шаруашылығы, клининг, тері-былғары мен тоқыма өнеркәсібінде қолданылады.
– Бұл ретте глутар альдегиді әсері өте күшті ақуыз денатураторы ретінде тірі материямен әрекеттеседі. Препарат медициналық практикада және санитарияда жетекші рөлге ие болмады, себебі оның адам мен жануарлардың шырышты қабаттары мен жоғарғы тыныс алу жолдарына қатты тітіркендіргіш әсері бар. Аллергендік қасиеті де жоғары. Оның салдары экземалар, нейродермиттер түрінде көрінеді, – деді О.Бектенов.
Осы уды бүкіл Қазақстан территориясына шашып шықса, ертең халық денсаулығынан «сау-тамтық» қалмауы мүмкін. Содан Үкімет тізгін тартып отыр. Пандемия кезінде бірқатар көшеге қолмен у шашып, дезинфекциялау жүргізілгенде соның өзі елдің үрейін ұшырғаны мәлім.
Премьердің мәліметінше, химиялық өнімнің қауіпсіздік паспортына сәйкес, келесі жайттар анықталды: өңірлерді «БА-12» дезинфекциялау құралымен жаппай өңдесе, біріншіден, жұртшылықтың глутар альдегидін деммен жұту қаупі бар. Бұл зат небәрі +20°C температурада буланған кезде ауаның ластануының қауіпті деңгейіне тез жетеді.
Екіншіден, ұзақ жыл бойы және қайталай әрекет ету әсеріне ие. Салдарынан, жергілікті тұрғындардың қайта-қайта немесе ұзақ уақыт бойы тыныстауы олардың арасында демікпе мен дерматиттің кең таралуына соқтырады.
Үшіншіден, бұл зат – қатерлі ісікке соқтыра алатын канцероген: ұзақ уақыт әсер еткенде ықтимал канцерогендігі туралы ақпарат бар. Төртіншіден, қоршаған ортаға залалы да жетерлік. Зат, әсіресе суда өмір сүретін организмдер, балықтар, басқасы үшін өте улы, қауіпті.
Бесіншіден, елде кейінгі жылдары дала, орман өрттері жиіледі, бұл зат өрт кезінде тітіркендіргіш немесе уытты бу (газ) шығарады. Алтыншыдан, глутар альдегидінің өзге де экологиялық тәуекелдері жоғары. Оны қолданудың негізгі қауіптерінің бірі – оның ағынды су арқылы су объектілеріне сіңу қабілеті. Бұл зат табиғи жағдайда нашар ыдырайды. Мұнысы су экожүйесіне жойқын әсер етіп, өзендерде, көлдерде, Каспий теңізінде улы концентрациялардың жиналуына соқтыруы мүмкін.
Жетіншіден, Қазақстан соның көмегімен сібір жарасы ошақтарынан құтыламын десе, Ұлы даладағы биоәралуандықты құртып тынуы мүмкін. Өйткені қоршаған ортаға түскенде глутар альдегиді қоректік тізбектің негізі саналатын барлық микроорганизмді өлтіреді. Бұл биоәралуандықтың төмендеуіне әкеліп, бүкіл экожүйеге теріс әсер етпек.
Халықаралық тәжірибеде глютар альдегиді әдетте медициналық аспаптарды дезинфекциялау үшін 2-3% концентрацияда ғана қолданылады. Ал «БА-12» дезинфекциялау құралында оның шоғырлануы – кем дегенде 10%!
Премьер Олжас Бектеновтің айтуынша, глютар альдегидінің халыққа, қоршаған ортаға зиянын, уыттылығын, тератогенділігін және канцерогенділігін ескеріп, әсіресе елді мекендер аумағындағы сібір жарасы ошақтарын онымен өңдеуден бас тартылды. Ендеше күйдіргіні жұқтырмау үшін халықтың әрі қарай да дәстүрлі алдын алу шараларын қолдануы маңызды.
Айхан ШӘРІП